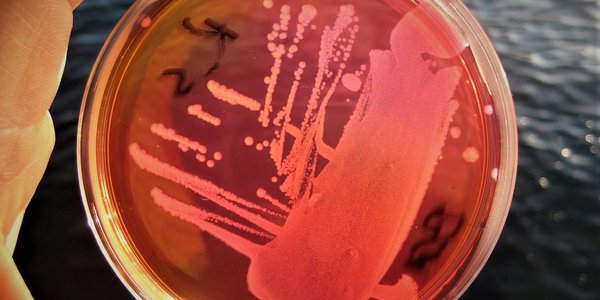
C:\Users\kjersti\Desktop\Bakterier fra sjømat.jpg

Tema: Overvåkning av sjømat

Publisert: 27.03.2019 Oppdatert: 12.02.2025
I Norge er det Mattilsynet som står for prøvetakingen av oppdrettsfisk, mens det er Havforskningsinstituttet som analyserer prøvene og rapporterer til Mattilsynet.
I tillegg til den årlige overvåkningen av oppdrettsfisk har Havforskningsinstituttet siden 2006 gjennomført store kartleggingsundersøkelser, såkalte basisundersøkelser, av kommersielt viktige arter som torsk, sild, makrell og sei. I tillegg er det gjort basisundersøkelser for noen arter som har risiko for overskridelse av grenseverdier, som blåkveite, kveite, brosme, lange og krabbe.
HI overvåker også mengden parasitter i fisk. Les mer om det under parasitter.
Slik overvåkes villfisken
I en basisundersøkelse tas det prøver i en størst mulig del av området der arten fiskes. Målet er å dekke variasjonen av miljøgifter med faktorer som geografi, årstid og alder. Basisundersøkelsene gir oversikt over nivåene av uønskede stoffer i de ulike artene langs norskekysten.
Resultatene fra basisundersøkelsene danner også grunnlaget for en oppfølging av hver enkelt art. Oppfølgingen pågår med årlig prøvetaking i de ulike havområdene av torsk, sei og makrell, og prøvetaking hvert tredje år av sild i Nordsjøen og Norskehavet. Noen arter har så liten kommersiell betydning at det ikke blir gjennomført en basisundersøkelse på disse, men prøvetakingen blir i stedet gjort som stikkprøver.
Slik overvåkes oppdrettsfisken
Havforskningsinstituttet analyserer årlig innholdet av uønskede stoffer i oppdrettsfisk for Mattilsynet. Mattilsynet tar tusenvis av prøver som skal være representative for oppdrettsfisken som produseres i hele Norge. Tidligere har det vært tatt prøver fra omtrent 12000 oppdrettsfisker hvert år. Prøvetakningsmetoden er nå noe endret slik at det tas prøver av færre fisker, men det blir gjort flere analyser.
Antall prøver er regulert gjennom lovverket. En detaljert oversikt over antall, analyser og resultater finnes i den årlige overvåkningsrapporten vi publisererer som nettrapport (Se oversikten nettrapporter - overvåkingsgruppens rapporter)
Dersom Havforskningsinstituttet finner uønskede stoffer i fisken som ligger over nivåene som EU har satt, blir Mattilsynet varslet. Om nødvendig iverksetter Mattilsynet tiltak, som advarsler og begrensinger.
Slik overvåkes fiskefôret
Havforskningsinstituttet overvåker årlig fiskefôr på oppdrag for Mattilsynet. Prøver blir tatt fra fôrprodusenter fra fabrikker på ulike steder i landet, og på ulike tidspunkt av året. Fôret og fôringrediensene, både marine og vegetabilske, analyseres for både uønskede stoffer og næringsstoffer. Målet er å få et representativt utvalg av fiskefôr og fôringredienser som blir brukt i norsk fiskefôrproduksjon, og kartlegge potensielle farer knyttet til fiskefôr som kan være en risiko for folkehelse, fiskehelse, fiskens velferd eller som kan føre til skader på miljøet.
Norge følger fôrlovgivningen i EU. Denne blir jevnlig endret og oppdatert i samsvar med forandringer i EUs fôrlovgivning. Resultatene av fôrovervåkningen publiseres i en egen, årlig nettrapport. (Se oversikten nettrapporter - overvåkingsgruppens rapporter)
Grenseverdier i sjømaten
En grenseverdi for et stoff i en matvare angir den maksimale mengden av stoffet som er tillatt i et produkt som skal selges som mat. Disse grenseverdiene kan ikke betraktes som grenser for helseskade, men er laget for å forhindre at produkter med for høye verdier av fremmedstoffer når frem til forbrukeren. Grenseverdier for et uønsket stoff kan være forskjellige fra matvare til matvare.
Det er EU-kommisjonen som fastsetter reglene for grenseverdier i mat, mens Mattilsynet forvalter reglene i Norge.
Tolerabelt ukentlig inntak – TWI
Tolerabelt ukentlig inntak (TWI) beskriver den mengden stoff en person kan få i seg ukentlig gjennom hele livet uten fare for negative helseeffekter. Tolerabelt ukentlig inntak brukes for organiske miljøgifter og tungmetaller, og uttrykkes per kilo kroppsvekt.
Akseptabelt daglig inntak – ADI
Akseptabelt daglig inntak (ADI) beskriver den mengden stoff et menneske kan få i seg daglig gjennom livet uten fare for negative helseeffekter. ADI brukes for tilsetningsstoffer og pesticider som lovlig kan tilsettes i mat eller som kan brukes i matproduksjonen. Før stoffene kan tas i bruk, må effekten av dem ha vært vurdert og stoffene må være godkjent av myndighetene.
Hvordan fastsettes tolerabelt ukentlig inntak og akseptabelt daglig inntak?
Vurderingene gjøres av internasjonale ekspertkomiteer, for eksempel EFSA (European Food Safety Authority) og JECFA (Joint FAO/WHO Expert Committee on Food Additives).
Fastsettelsen av tolerabelt ukentlig inntak for mennesker gjøres på bakgrunn av befolkningsstudier, eller dyrestudier som er gjort på den mest følsomme arten for det aktuelle stoffet. Når det høyeste nivået av et stoff som ikke gir noen uheldig effekt på forsøksdyr er fastsatt, legges det inn sikkerhetsmarginer før verdien fastsettes for mennesker. Sikkerhetsmarginen tar høyde for at det kan være variasjon fra art til art, og fra individ til individ.